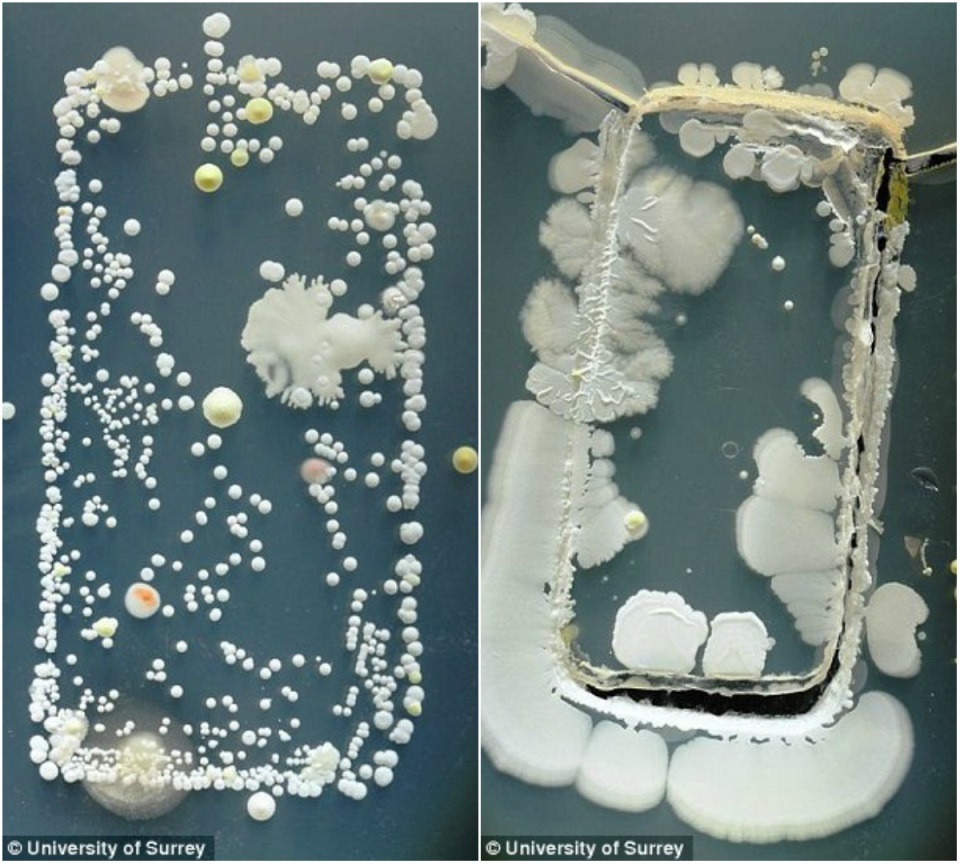
Профессии медицины будущего - 2 Профессии медицины будущего - 2

Мы много говорим про нейронные сети и развитие искусственного интеллекта, но не будем забывать, что новый виток технического прогресса затрагивает и другие области. Борьба со старением, бессмертие, снижение стоимости медицинских услуг — все это часть огромного океана возможностей, превращающих мир в идеальное место для жизни и творчества.
Биотехнологии и медицина быстро развиваются, и вполне возможно, что через несколько лет будут нуждаться в профессионалах, специализацию которых сегодня трудно вообразить. Если вы сейчас сомневаетесь в выборе профессии или хотите кому-то посоветовать сделать в жизни правильный выбор, обратите внимание на медицину. Не медицину сегодняшнего дня, а ту перспективную отрасль, в которой IBM Watson ставит диагноз в каждой районной поликлинике.
Персональный управляющий микрофлорой
Огромное число бактерий живут в нас и на наших вещах. На телефоне содержится в 18 раз большее число бактерий, чем на ручке слива в мужском общественном туалете.
Мы только начинаем осознавать всю сложность взаимосвязи нашего бытия и триллионов микроскопических организмов, живущих внутри и на нас. На данный момент учёные предполагают, что сообщества микроорганизмов влияют на все аспекты нашей жизни, от массы тела до степени бодрости и психического здоровья.
Полное исследование химических веществ, содержащихся на коже человека, показало, что многие из них являются остатками косметических средств по уходу за кожей. Это внушает опасения, что всевозможные искусственные химические соединения разрушают экосистему микрофлоры кожи. Можно предположить, что в будущем появятся специалисты, которые будут помогать людям быть настоящими «пастырями» для своей микрофлоры, обучая, как её нужно взращивать, отбраковывать и поддерживать баланс.
Продолжаются попытки прямо сейчас сделать с бактериями что-то полезное. Генетик Сет Шипман из Гарвардского университета совместно с коллегами разработал технологию записи данных в ДНК бактерий. Теоретический предел плотности хранения информации в ДНК составляет 1 млрд Гб на кубический миллиметр. До сих пор ученые могли внести в живую клетку максимум 11 байт данных, однако Шипману удалось увеличить это число почти в десять раз.

JuicyPrint – это активно развивающийся проект по созданию светочувствительных бактерий. Бактерии производят целлюлозу, и с некоторыми правками в генетическом коде их можно заставить реагировать на свет. Посветите на них, и начинается производство целлюлозы. Уберите свет – производство останавливается. С появлением биологически совместимой и прочной субстанции, которую можно воспроизводить и печатать с помощью света, откроются совершенно новые возможности для медицинских технологий. Технологию можно будет использовать для чего угодно, от регенерации органов до создания новых артерий и сосудов.
Консультант по подбору признаков

Китайские ученые сообщили об успешной коррекции генов человеческого эмбриона. В частности, они работали с геном CRISPR/Cas9, ответственным за возникновение β-талассемии. Это стало первым задокументированным вмешательством в человеческий геном, спровоцировавшим очередной всплеск дебатов относительно этичности подобных манипуляций.
Фильм «Гаттака», работа консультанта по подбору признаков.
Несмотря на сильное сопротивление общественности, вряд ли удастся остановить исследования по модификации нашего генома. Когда-нибудь этим будут заниматься не только для устранения каких-либо заболеваний и мутаций, но и для улучшения каких-то черт совершенно здоровых эмбрионов. И пора уже задуматься о том, как нам в долгосрочной перспективе регулировать будущий рынок услуг по изготовлению людей на заказ. В том числе, как работать с родителями, желающими генетически улучшить своих детей. Консультант по подбору признаков мог бы объяснять границы законности при вмешательстве в геном и помогать советами, что и как можно изменить в каждом конкретном случае.
Специалист-реинтеграторы по выгрузке разума

Если наше сознание закодировано в структуре и активности , то, как только мы научимся составлять подробную схему взаимодействия всех нейронных связей, будет возможно создавать копии в другом подходящем носителе. Например, в суперкомпьютере.
Выгрузка человеческого разума кем-то рассматривается как один из возможных путей развития человеческой цивилизации. Но это может быть и эффективным способом «временного хранения» разумов людей, чьи тела были уничтожены или повреждены, пока для них готовят новые тела.
Кто знает, какие трансформации могут произойти с человеческим сознанием, пока его перегоняют из плоти в кремний и обратно. Особенно когда человек приходит в себя в новом теле в совершенно изменившемся мире. Специалисты-реинтеграторы могли бы помогать «прибывшим» из суперкомпьютеров адаптироваться как физически, так и социокультурно. Возможно, для этого будут использоваться своеобразные карантинные цифрофизические зоны, облегчающие для разумов переход из цифрового бытия в физическое. Чтобы они вновь привыкли к тому, что они живут, дышат, у них есть тела со всеми их достоинствами и недостатками.
Телехирург

Телехирургия — это проведение операции с помощью роботизированной установки, которой удалённо управляет врач. Подобное оборудование уже существует и вполне себе действует. Но одним из главных препятствий на пути в светлое телехирургическое будущее является очень высокая стоимость установок. Если в будущем удастся многократно удешевить эти системы, то это позволит решить проблему нехватки высококвалифицированных хирургов. К тому же, пациентов удобнее везти к ближайшей телеоперационной, а не в крупные города и медицинские центры.
Развитие робототехники позволит существенно повысить возможности самих установок, частично автоматизировав рутинные хирургические операции. Можно даже представить себе появление мобильных телеоперационных, способных оказывать помощь в труднодоступных районах, а также в зонах бедствий.
Специалист по выращиванию органов

Уже сегодня нехватка донорских органов является огромной проблемой, породившей теневой криминальный рынок. В США на 28 000 доступных для пересадки органов приходится 120 000 нуждающихся в год. Согласно оценкам, около 35% смертей можно было бы предотвратить, сделав вовремя пересадку органа. Так что сейчас очень велик интерес к выращиванию органов в лабораторных условиях.
С развитием восстановительной медицины растут и наши возможности по «производству» органов. Один из лидеров в этой сфере, компания Organovo разработала биологический 3D-принтер. Исследователи уже смогли создать ткани искусственной печени, практически идентичные натуральным как по строению, так и по функциям.
Также исследуется иной подход, когда на 3D-принтере создаётся своеобразный «каркас» органа, — сердца, печени, почки или лёгкого, — а затем с помощью стволовых клеток пациента наращиваются недостающие ткани. Получается совершенно новый орган, уже готовый к трансплантации. Так что вполне можно надеяться, что в будущем это станет массовым явлением.
Дизайнер синтетических протеинов

Население планеты быстро растёт, а учитывая ограниченность ресурсов по производству продуктов питания, мы относительно скоро можем столкнуться с нехваткой еды в планетарном масштабе. Согласно данным ООН, среднемировое потребление мяса на душу населения выросло вдвое с 1961 по 2007 годы. А к 2050-му ещё удвоится. Но бесконечно увеличивать стада зверюшек не получится, поскольку их тоже надо кормить и поить, а с посевными площадями и пресной водой тоже ожидается напряжёнка. Так что много предпосылок для разработки технологий массового производства синтетических протеинов.
В этой сфере уже отметились стартапы Modern Meadow и Beyond Meat. Они исследуют возможность выращивания мяса in vitro, а также создания мясозаменителей.
Специалист по возрождению животных видов

Сегодня по всему миру немало научных коллективов ломают голову над тем, как возродить различные виды вымерших животных. Было уже немало спекуляций на тему выведения подобия мамонтов, мечтали даже о воссоздании некоторых динозавров. Но для этого придётся решить труднейшие проблемы, вроде восстановления деградировавшей доступной ДНК, сохранившейся в останках и окаменелостях, оплодотворения и вынашивания с непредсказуемыми результатами. Хотя цель у всего этого весьма благородная — восстановление и сохранение разрушенных участков экосистемы планеты.
Возьмём тех же мамонтов. Если удастся создать животных, близких к древним волосатым слонам, то с их помощью можно было подготавливать засушливые пустынные территории к лесовосстановлению. Правда, совершенно неизвестно, как воссозданные виды будут существовать в новых экосистемах, к которым они когда-то так и не смогли приспособиться. И здесь неоценимую помощь могут оказать специалисты по возрождению видов, которые будут управлять адаптацией животных к окружающим условиям, попутно предотвращая нежелательное воздействие на существующие экосистемы.
Специалист по обслуживанию биомеханических систем (медханик)

Для татуировщика, потерявшего руку, создали необычный протез со встроенной тату-машиной.
Фантастика и кинематограф продолжают готовить нас к появлению киборгов. Да что там, они уже фактически появились: взгляните на современные высокотехнологичные протезы. И в будущем синтез живого и искусственного сможет принимать удивительные формы. А столь сложные и незнакомые человечеству конструкции нужно кому-то обслуживать. Такие специалисты должны иметь не только медицинское образование, но и быть способными работать со сложной прецизионной механикой и электроникой.
Такие «медханики» могут выезжать на дом к заказчикам, либо принимать их в специализированных салонах-мастерских. Своеобразный аналог автосервиса, только для людей с протезами, имплантатами и комплексными модификациями тела. Скорее всего, появятся и специалисты по психологической адаптации киборгов. Ведь люди без искусственных частей тела вряд ли поймут потребности и нужды киборгов, а спрос породит и предложение.
Мастер-фармацевт

Ноотропики появились в 1964 году с химического коктейля под названием «пирацетам». Созданное румынским химиком и психологом Корнелием Джиургеа лекарство положило начало современным ноотропикам. Согласно Джиургеа, с помощью лекарств можно улучшить когнитивные способности, а также увеличить активность между полушариями
Возможно, развитие персонализированной медицины, доступность генной инженерии и возможность быстрой разработки лекарственных средств приведут к появлению рынка создаваемых по заказу лекарств, предназначенных для конкретных заказчиков. Разрабатывать крохотные партии таких средств будут мастера-фармацевты, предварительно изучившие генетику клиента, историю болезней, социоэкономическую среду, привычки и распорядок дня, и т.д.
Архитектор коннектомов

Плотность нейронов в человеческом
В общем, связей между нейронами ОЧЕНЬ много. Схема, описывающая эти связи, называется коннектомом. И задача построения полного коннектома человеческого мозга по праву считается одной из сложнейших.
Вероятно, в будущем она будет решена. Если нам удастся создать полный коннектом, то это позволит понять происхождение многих заболеваний
* * *
Футуристам редко выдаётся шанс воскликнуть «Я же говорил! Я ещё 40 лет назад предсказывал». Зато следующие поколения удивляются прозорливости авторов предсказаний. Кто знает, может что-то из вышеописанного станет реальностью. Возможно, даже раньше, чем к середине века.
Согласно «Атласу новых профессий» до 2050 года появятся 186 новых профессий, из них 16 в области медицины. При этом акцент внимания медицины изменится в сторону поддержания здоровья. Нам остается только дожить до этого прекрасного времени.
Автор: Mail.Ru Group
